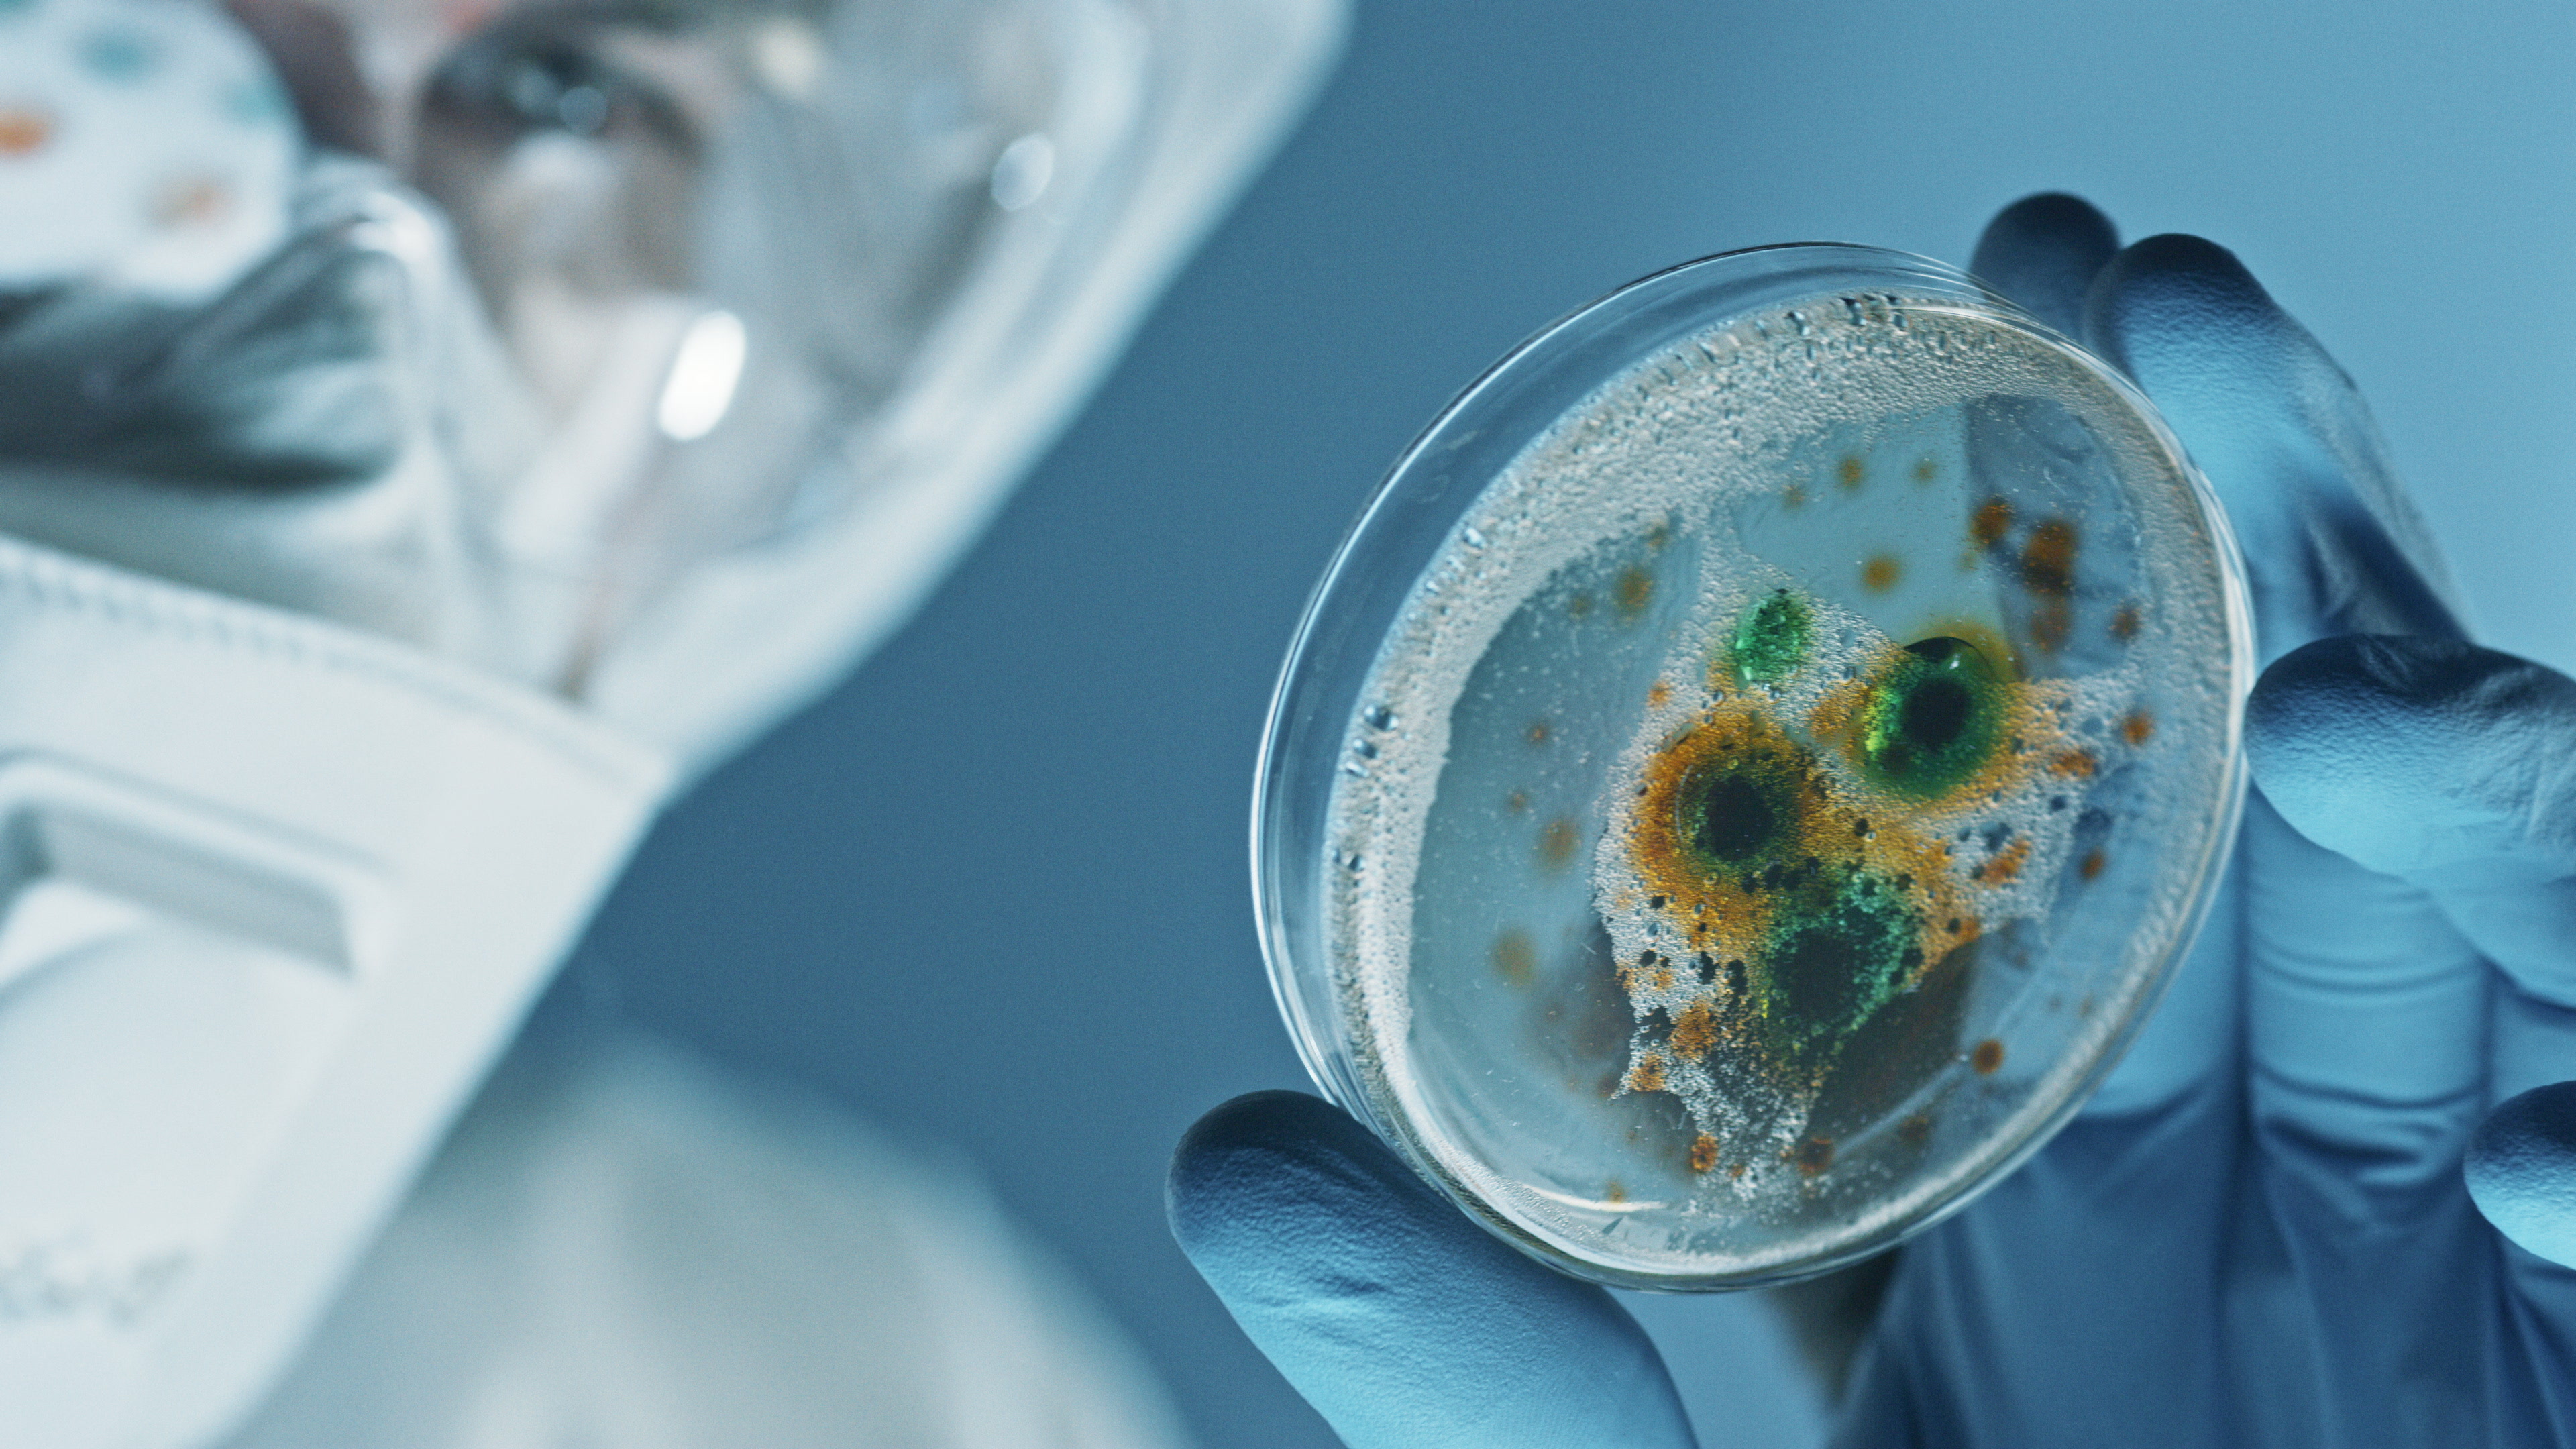
Enterprise infrastructure

Your competitors are using AI. You know you should be. You don't know where to start.
58% of small businesses are already using generative AI. But most are stuck at the ChatGPT-on-a-browser stage — no integration, no training, no strategy. The gap between "using AI" and "AI running your workflows" is where productivity actually lives. We've worked inside regulated operations — we know what compliance frameworks look like, why teams resist new tools, and what it takes to make adoption stick.

- Your team doesn't know what to ask it. AI is only as useful as the person prompting it. Without training, your staff will try it once, get a mediocre answer, and go back to doing things the old way.
- Off-the-shelf tools don't fit your operations. Every business has specific documents, terminology, procedures, and data. Generic AI doesn't know your SOPs, your customer history, or your compliance requirements.
- Nobody owns the AI initiative. IT thinks it's a business decision. Leadership thinks it's an IT project. Meanwhile your competitors are automating proposals, scheduling, compliance lookups, and customer intake.
- You're leaving money on the table. State and federal programs are actively funding AI workforce training and technology adoption for small businesses right now. The programs exist — most businesses don't know they qualify.